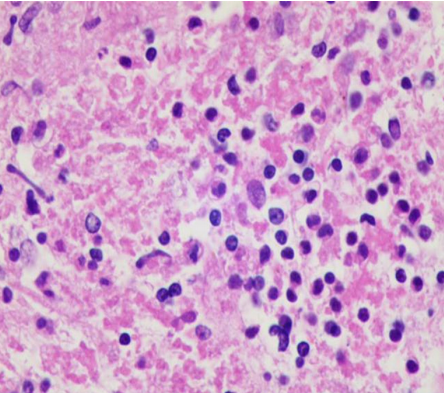
20230607102416_2139.png

细胞块制备试剂盒在眼内玻璃体液细胞学检查中的应用
阅读量:6789
DOI:10.3978/j.issn.1000-4432.2021.07.07
发布日期:2023-06-07
作者:
陈淑霞 ,林健贤 ,高欢欢 ,唐丽娟 ,张文忻 ,李永平 ,张平
展开更多 '%20fill='white'%20fill-opacity='0.01'/%3e%3cmask%20id='mask0_3477_29692'%20style='mask-type:luminance'%20maskUnits='userSpaceOnUse'%20x='0'%20y='0'%20width='16'%20height='16'%3e%3crect%20id='&%23232;&%23146;&%23153;&%23231;&%23137;&%23136;_2'%20x='16'%20width='16'%20height='16'%20transform='rotate(90%2016%200)'%20fill='white'/%3e%3c/mask%3e%3cg%20mask='url(%23mask0_3477_29692)'%3e%3cpath%20id='&%23232;&%23183;&%23175;&%23229;&%23190;&%23132;'%20d='M14%205L8%2011L2%205'%20stroke='%23333333'%20stroke-width='1.5'%20stroke-linecap='round'%20stroke-linejoin='round'/%3e%3c/g%3e%3c/g%3e%3c/svg%3e)
关键词
细胞块制备试剂盒
玻璃体液
苏木素-伊红染色
摘要
目的:探索用细胞块制备试剂盒对眼内玻璃体液微量细胞制备细胞块的成功率,苏木素-伊红(hematoxylin-eosin,HE)染色效果及技术要点。方法:收集中山大学中山眼科中心临床病理科2020年9月至2021年1月由临床送检的25例玻璃体液(含玻璃体切割液),应用细胞块制备试剂盒制备细胞块后,常规固定、脱水、包埋、切片,随后进行HE染色,观察染色效果。结果:25例玻璃体细胞蜡块制作成功率达到100%,制片后HE染色效果好,背景干净,细胞形态清晰,核质对比分明。结论:应用细胞块制备试剂盒能将眼内玻璃体液微量细胞制成蜡块,极大提高了标本的利用率,为后续的病理研究提供丰富的材料。
全文
以往针对临床送检的玻璃体液处理多以细胞涂片法和离心直接取细胞沉渣包埋法为主,但在长期实践中发现,细胞涂片法会因为涂片厚薄不均而出现细胞堆积重叠、细胞分散、细胞形态结构不清,有背景染色等情况,造成阅片及诊断上的困难;离心直接取细胞沉渣包埋法对标本量的要求比较大,适用于送检量多且离心后肉眼可见细胞沉淀多的玻璃体切割液,不适合送检量少或细胞量少的玻璃体液。随着临床对病理诊断要求的不断提高[1-2],将玻璃体液中的微量细胞沉淀制成细胞块的技术运用十分关键,它在细胞学研究与病理的诊断中起非常重要的作用[3-4]:不仅能为细胞学诊断提供更加完整的信息和清晰的形态结构,还可用于免疫组织化学染色,特殊染色等辅助检测手段。本研究收集2 5例玻璃体液(包括玻璃体切割液)为研究对象,探讨改良型细胞蜡块的制作及染色在玻璃体液病理诊断中的应用价值。
1 材料与方法
1.1 材料
1.1.1 标本来源
收集2020年9月至2021年1月临床送检至中山大学中山眼科中心临床病理科的玻璃体液(含玻璃体切割液)25例。
1.1.2 仪器与试剂
低速离心机购自上海安亭科学仪器厂,干式恒温器购自昆明东环科技有限公司,全自动密闭式组织脱水机购自德国Leica公司,细胞块制备试剂盒购自昆明东环科技有限公司。
1.2 方法
标本处理前,打开干式恒温器进行预热,并将细胞块制备试剂盒中配备的专用离心管置于干式恒温器上(图1),使专用离心管中的基质加热熔化,保持在85 ℃备用。接着处理标本及制作细胞块:1)将临床送检的玻璃体液转移至5 mL的离心管中,2 000 r/min离心5 min;玻璃体切割液(混有组织块时,需将组织块取出单独包埋)则分批转移至50 mL的离心管中,2 000 r/min离心5 min,吸去上清液,合并所有离心管的微量细胞沉渣,再次离心。2 )离心完成后,用吸管吸去上清液,离心管内留下细胞沉淀(此时混匀后涂片一张用于做对照)。3 )之后加入5倍以上体积的细胞固定液,用吸管将细胞沉淀轻轻吹打成分散的细胞或细胞团,预固定10 min。4 )取出事先在干式恒温器上预热的专用离心管,基质完全液化后,打开红色离心管盖,将预固定的细胞固定液混悬液加入专用离心管中,用吸管反复吹打使细胞混悬液和基质充分混匀。加样量:直径8 mm专用离心管,加样量约1 000 μL;直径4 mm专用离心管,加样量约400 μL。5 )趁热立即离心,将离心管头透明端向下,1 500 r/min离心5 min。离心完成后,将专用离心管置于4 ℃冰箱10 min以上,使基质充分凝固。6 )取材:打开两端离心管盖,撕去密封膜,用棉签将含有细胞的基质推出离心管,用刀片切下3 mm厚细胞端,最下层细胞向下放入塑料包埋盒中(最下层细胞含有细胞团和大细胞)。7 )将制成的细胞块在全封闭组织脱水机中进行脱水,透明与浸蜡,用石蜡包埋机制备成细胞蜡块,常规切片并行HE染色,必要时进行免疫组织化学染色及特殊染色。


图1 专用离心管置于干式恒温器上加热熔化
Figure 1 Special centrifugal tube is heated in a dry thermostat
2 结果
2.1 肉眼观察
经过上述过程制作而成的细胞块是呈果冻样的圆柱胶体,经处理后制备成蜡块(图2 ),肉眼可见细胞块与蜡融合良好,两者之间未见裂隙。细胞蜡块硬度好,包埋面形状规则,切片完整(图3)。



图2 细胞块制备试剂盒制备的细胞蜡块
Figure 2 Cell paraffiffiffin blocks made with cell block preparation kit

图3 本方法制片时切片完整
Figure 3 Slices are complete with this method
2.2 显微镜下观察
与传统涂片法对比,传统涂片法制片后H E染色可见细胞成堆分布不均匀,细胞堆叠严重,结构欠清晰,难以区分细胞形态(图4 )。应用试剂盒制备的细胞蜡块制片后进行HE染色,效果好(图5,6 ),细胞数量分布适中,细胞之间分散且均匀平铺,细胞形态结构清晰,细胞核和细胞质着色良好,连续切片中细胞成分分布均匀,背景干净。




图4 传统涂片法细胞分布不均匀,细胞堆叠严重时难以区分形态(HE,×400)
Figure 4 The cells are not evenly distributed, and the morphology of the cells is not clear with the traditional smear method (HE, ×400)

图5 细胞数量分布适中,核质对比分明,形态清晰,可见肿瘤细胞(箭头;HE,×400)
Figure 5 Cells are evenly distributed, and the morphology of the tumor cells is clear with cell block preparation kit (arrows; HE, ×400)
图6 细胞之间分散且均匀平铺,可见炎症细胞(HE,×400)
Figure 6 Cells are evenly distributed, and the morphology of the inflammatory cells is clear with cell block preparation kit (HE,×400)
3 讨论
玻璃体液细胞蜡块制备是细胞学检查重要的组成部分,是对细胞涂片诊断的有力补充,能满足免疫组织化学染色和特殊染色检测的需要,为提高细胞学诊断的正确性提供更多诊断依据[5-7]。目前针对细胞块的制作技术并没有统一标准,在不同病理科及实验室所用的细胞块制备技术不尽相同。本科室接收的玻璃体液标本,根据切割液中细胞含量选择直接离心取细胞沉渣包埋法或细胞块制备试剂盒法。离心取细胞沉渣包埋法制备细胞蜡块虽然是较为简单的方法,但适用于送检量大且细胞沉淀多的玻璃体切割液,离心后沉淀物聚集不易分散;对于送检量少或细胞量比较少的玻璃体液用此法制作细胞蜡块制片后效果不佳,究其原因,离心沉渣法是直接取离心后的沉渣物进行固定脱水包埋,由于沉渣物量少且细胞中间缺乏一定的支架,离心时细胞难以聚集成团,且在利用吸管将离心管底部的微量沉渣转移至包埋纸的过程中,沉渣碎裂,吸管及离心管附着较多细胞,脱水后包埋纸中仍贴附有部分细胞[8],导致最后细胞的富集效果不理想,从而影响制片与诊断。
细胞块制备试剂盒法直接弥补了离心取细胞沉渣包埋法的不足之处,能将送检量少细胞量少的玻璃体液制作成细胞蜡块,防止细胞丢失。此方法中的关键基质材料与琼脂糖作用相似,首先将专用离心管加热使基质液化,用液态基质作为分离富集的介质材料,降低温度后,冷却凝固的固态基质作为支架材料,将在液态条件下分离富集的细胞、细胞团,支撑凝固在特定的空间位置。琼脂糖包埋法是文献[8-9]报道中使用较多的方法,但由于该方法存在需现配琼脂、温度和浓度不易掌握,操作步骤繁琐,操作过程受人为的影响因素大等缺点,没有在玻璃体液细胞学检查中进行广泛应用。而细胞块制备试剂盒法操作步骤简单,通过温度和时间的可控,最大限度地避免人为操作带来的误差,提高标本制片满意率。另外,试剂盒中配有两种不同内径的专用离心管,当送检的玻璃体液沉渣物较多时,可选择内径8 mm的专用离心管进行制备细胞块。当送检的玻璃体液沉渣物较少时,使用小内径的专用离心管能够将微小标本聚集制作成细胞块。
采用细胞块制备试剂盒技术制作的细胞蜡块,有如下优点:可对微量标本进行处理,提高利用率;制备的细胞块完整,基质与石蜡之间无裂痕;细胞块切片顺畅,满足标本连续切片,为免疫组织化学染色、特殊染色等检测提供丰富的切片,有利于后续的诊断和研究;并可永久保存标本。但应用过程中应该注意以下几点:1 )当送检的玻璃体液离心后沉渣物肉眼不易观察时,应适当提高离心机转数或多次离心富集,直至满足要求。2 )若送检的眼内液体外观是红色或深红色,则需要向细胞沉渣物中加入5倍以上的红细胞裂解工作液,消除大量红细胞造成的背景干扰,有利于提高肿瘤细胞或炎症细胞等的检出率。3 )用小吸管轻柔地将细胞混悬液与基质充分混匀后,应该立即趁热离心。此步骤需快速完成,否则温度降低,细胞与基质凝胶体没有离心便先形成凝固,影响细胞的分离富集效果。4 )待基质凝胶体凝固后,用棉签推出,棉絮轻软,有利于保护细胞不受挤压、基质凝胶体不易破碎等。5 )由于细胞是有序分布,大细胞,高核质比细胞,细胞团在最下层,因此必须将细胞块的最下端作为包埋面,包埋时应轻夹轻放,切片时应轻修少修,以免造成细胞的损失。6 )试剂盒制备的细胞蜡块制片做免疫组织化学染色前,烤片时间适当加长、温度设为65 ℃以上,使细胞有效黏附于玻片上,防止脱片。
综上所述,应用细胞块制备试剂盒处理眼内玻璃体液的操作过程简单方便,可连续切片,不仅满足常规病理诊断的需求,还可用于后续免疫组织化学染色和特殊染色的检测,为临床提供了有价值的细胞学诊断结果。
基金
暂无基金信息
参考文献
1. 狄宇, 叶俊杰. 诊断性玻璃体切除术的研究进展[ J]. 协和医学杂
志, 2019, 10(2): 152-156.
DI Y, YE JJ. Development of diagnostic vitrectomy[ J]. Medical Journal of Peking Union Medical College Hospital, 2019, 10(2): 152-156.
DI Y, YE JJ. Development of diagnostic vitrectomy[ J]. Medical Journal of Peking Union Medical College Hospital, 2019, 10(2): 152-156.
2. 林壮玲, 张平. 视网膜母细胞瘤诊疗的研究进展[ J]. 眼科学报,
2020, 35(4): 271-278.
LIN ZL , ZHANG P. Research progress on the diagnosis and treatment of retinoblastoma[ J]. Yan Ke Xue Bao, 2020, 35(4): 271-278.
LIN ZL , ZHANG P. Research progress on the diagnosis and treatment of retinoblastoma[ J]. Yan Ke Xue Bao, 2020, 35(4): 271-278.
3. 陈颖, 平波, 王龙富, 等. 细胞病理学在经支气管镜超声引导针吸
活检术中的作用[ J]. 中华病理学杂志, 2012, 41(1): 44-47.
CHEN Y, PING B, WANG LF, et al. Value of cytopathology in endobronchial ultrasound-guided transbronchial needle aspiration[ J]. Chinese Journal of Pathology, 2012, 41(1): 44-47.
CHEN Y, PING B, WANG LF, et al. Value of cytopathology in endobronchial ultrasound-guided transbronchial needle aspiration[ J]. Chinese Journal of Pathology, 2012, 41(1): 44-47.
4. 王怡璇. 常规细胞涂片法与细胞块免疫组化法检验胸腔积液的
临床价值比较[ J]. 基层医学论坛, 2020, 24(1): 94-95.
WANG YX. Comparison of the clinical value of conventional cell smear method and cell block immunohistochemical method in detecting pleural effusion[ J]. Public Medical Forum Magazine, 2020, 24(01): 94-95.
WANG YX. Comparison of the clinical value of conventional cell smear method and cell block immunohistochemical method in detecting pleural effusion[ J]. Public Medical Forum Magazine, 2020, 24(01): 94-95.
5. Richard K, Dziura B, Hornish A. Cell block preparation as a diagnostic
technique complementary to fluid‐based monolayer cervicovaginal
specimens[ J]. Acta Cytol, 1999, 43(1): 69‐73.
6. Keyhani‐Rofagha S, Vesey‐Shecket M. Diagnostic value, feasibility, and
validity of preparing cell blocks from fluid‐based gynecologic: cytology
specimens[ J]. Cancer, 2002, 96(2): 204-209.
7. 胡沙沙, 林东亮, 户燕姣, 等. 一种新型细胞蜡块制备技术应用体
会[ J]. 中华病理学杂志, 2019, 48(11): 890-892.
HU SS, LIN DL, HU YJ, et al. Experience in the application of a new cell block preparation technology[ J]. Chinese Journal of Pathology, 2019, 48(11): 890-892.
HU SS, LIN DL, HU YJ, et al. Experience in the application of a new cell block preparation technology[ J]. Chinese Journal of Pathology, 2019, 48(11): 890-892.
8. 张雪梅, 黄灵泉. 宫颈液基细胞块制备法的对比研究[ J]. 海南医
学, 2020, 31(19): 2522-2524.
ZHANG XM, HUANG LQ. Comparative study of preparation methods cervical fluid-based cell blocks[ J]. Hainan Medical Journal, 2020, 31(19): 2522-2524.
ZHANG XM, HUANG LQ. Comparative study of preparation methods cervical fluid-based cell blocks[ J]. Hainan Medical Journal, 2020, 31(19): 2522-2524.
9. 陈泳, 陈昌星, 杨清海. 细胞块制备技术及在实验室病理诊断应
用的研究进展[ J].福建医药杂志, 2018, 40(2): 133-135.
CHEN Y , CHEN CX , YANG QM. Research progress of cell block preparation technology and its application in laboratory pathological diagnosis[ J]. Fujian Medical Journal, 2018, 40(2): 133-135.
CHEN Y , CHEN CX , YANG QM. Research progress of cell block preparation technology and its application in laboratory pathological diagnosis[ J]. Fujian Medical Journal, 2018, 40(2): 133-135.
施引文献
1. 吴燕杏,毛荣军,莫超华等.黏蛋白乳化剂在1418例细胞蜡块制备技术中的应用研究[J].国际检验医学杂志,2023,44(2):200-204.